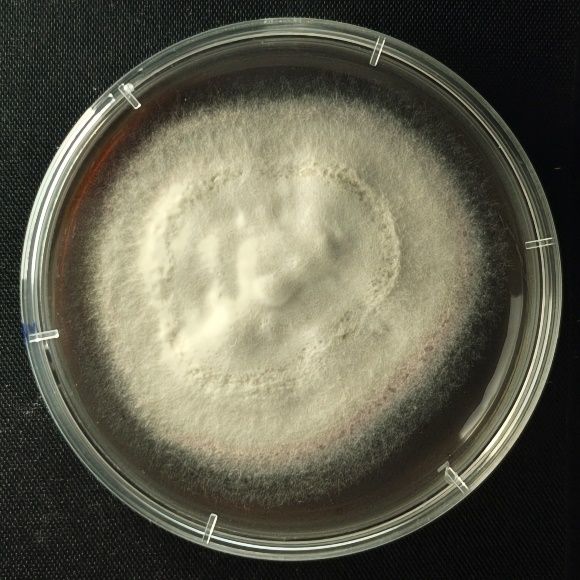
脚气为何反重复复总欠好？能够你踩这些“坑”里了！(图1)

严冬将至,在这热忱似火的时节里,气温的爬升在带来欢欣的同时,也能够让足癣这个不速之客静静找上门来。
足癣,也就是各人熟知的“脚气”,是临床上最多见的浅表真菌传染疾病。它不只给患者带来瘙痒、痛苦悲伤等不适感,还简单重复爆发,影响一样平常糊口和美妙。更严峻的是,足癣具有感染性,可经由过程多种路子感染给身旁的家人和伴侣。
足癣次要由皮肤癣菌惹起,此中以白色毛癣菌最为常见。这类皮肤癣菌的传布才能超强,经由过程打仗就可以传布。并且它对情况的顺应才能也凶猛得很,在枯燥的物体外表也能存活几个月。
设想一下,足癣患者几个月前穿过的公用拖鞋,都能够成为感染源。旅店、泳池、浴室、健身房、室等这些处所,职员活动大,情况湿润,恰是足癣传布的“重灾区”。以是,在这些场合必然要非分特别当心。

医治足癣脱皮鳞屑脚气泡脚用什么,次要依托抗真菌药物。关于大大都轻中度足癣,外用抗真菌药物就可以起到很好的结果,如酮康唑、特比萘芬等都是经常使用的药物。如果传染比力严峻的患者,能够思索口服抗真菌药物。不外,口服抗真菌药该当在大夫的指点下利用,出格是关于肝功用不全、妊妇或哺乳期妇女,利用时更要慎重。
小我私家卫生要做好:患者要天天改换鞋袜,制止重复传染。穿过的袜子最好用含氯消毒液消毒大概煮沸消毒。手打仗过患处后,也要用番笕大概洗手液当真洗濯。
足癣不实时医治或医治不完全,能够会招致病症连续减轻,并继发细菌传染。同时,皮肤癣菌能够会分散至其他部位(形成甲癣、体癣等)或感染给别人(特别是配合糊口者)。
制止光脚行走在大众浴室、泅水池、健身房等场合,只管不与别人共用鞋袜(包罗拖鞋),避免穿插传染;

许多人以为脚臭就是足癣,实在这是毛病的。脚臭能够由多种缘故原由惹起,如细菌传染、汗腺成绩等,而没必要然是真菌传染惹起的足癣。固然足癣能够会惹起脚臭,但脚臭并差别等于足癣。
有些患者以为足癣不消医治,本人就会好。实践上,足癣凡是不会自愈,假如不断止有用医治,传染能够会分散或变得愈加严峻。
许多人觉得足癣只会长在脚上,实在否则。假如患者搔抓后打仗其他部位的皮肤,足癣就可以够会分散得手部或其他部位,惹起体癣或手癣。
这里要给各人科普一下,脚气病(Beriberi)和足癣(俗称“脚气”)是两种完整差别的疾病,因中文称号类似常被混合。脚气病的素质是一种因持久缺少维生素B1(硫胺素)惹起的养分缺少病,和足癣可不克不及等量齐观。
有些患者利用皮炎对等激素类药膏后,觉得病症有所好转,就觉得用药有用了。实在,激素药膏其实不克不及杀灭真菌,反而能够抑止皮肤的免疫功用,使真菌发展更快,招致足癣减轻,更难治愈。
一些患者听信官方偏方,利用食醋、白酒等来医治足癣,但这些办法常常结果欠安,以至能够刺激皮肤,让病症变得更严峻。关于足癣,仍是要利用颠末考证的抗真菌产物停止医治。
有些患者以为那里痒就涂那里,这是不合错误的。足癣的医治该当笼盖全部足部,以至包罗四周安康的皮肤,如许才气避免真菌分散。
有些患者用药后病症有所改进,就自行停药了,这是毛病的做法。足癣的医治需求完玉成部疗程,不然简单复发。即便病症消逝,也应持续医治1-2周,确保完全肃清真菌。
期望各人都能理解这些关于足癣的常识,做好防备和医治,在炎天具有一双安康、温馨的双脚!/安康科普
出格声明:以上内容(若有图片或视频亦包罗在内)为自媒体平台“网易号”用户上传并公布,本平台仅供给信息存储效劳。
美伊将停止第二轮会谈,美防长:会谈底线是“伊朗不克不及够得到核弹”,对伊朗封闭已扩大至环球范畴,34艘船只在霍尔木兹海峡令折返
31人抢一辆严峻受损8400元起拍的小鹏汽车,有人出36800元拍下,法院称车主已在车祸中身亡
原村支书开铲车当着民警面把人埋了?网友质疑民警未实时避免;山西代县公安局:已向警督部分反应,正处理